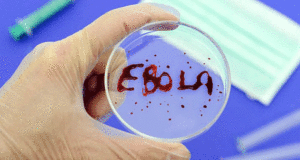

ضجت مواقع التواصل الاجتماعي بمجموعة صور رومانسية تجمع الفنان عمرو ...
أكمل القراءة »الرئيسية / أرشيف الكاتب: فريق التحرير (صفحة 2781)
ماكرون يبدي “استعداده لدعم” الحكومة الليبية الجديدة
أبدى الرئيس الفرنسي إيمانويل ماكرون الأحد “استعداده لدعم” الحكومة الليبية ...
أكمل القراءة »#الكونغو تعلن ظهور #فيروس_إيبولا مجدداً
أعلنت جمهورية الكونغو الديموقراطية الأحد ظهور فيروس إيبولا مجدداً في ...
أكمل القراءة »عبد الفتاح العلي: تسجيل حالة في المخفر لأي عرس أو حفل يقام في الجواخير أو المزارع أو قاعات الفنادق أو حتى بالمنازل
مع بدء تطبيق قرار مجلس الوزراء بتحديد ساعات العمل لكل ...
أكمل القراءة »استنفار أمني لمساندة «البلدية» و«التجارة» لتطبيق قرار مجلس الوزراء بإغلاق الانشطة التجارية
كشفت مصادر امنية مطلعة عن استنفار امني مساء اليوم لتنفيذ ...
أكمل القراءة » صحيفة خلف الكواليس موقع خلف الكواليس متخصص بالاخباري المحليه أول بأول
صحيفة خلف الكواليس موقع خلف الكواليس متخصص بالاخباري المحليه أول بأول